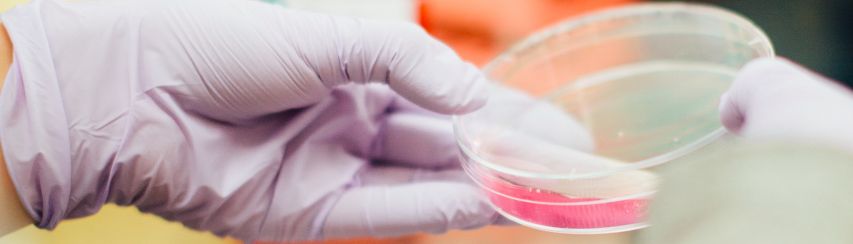

Le Laboratoire Ketterthill
Depuis plus de 70 ans, le Laboratoire Ketterthill constitue le partenaire santé privilégié pour les analyses de biologie médicale au Grand-Duché de Luxembourg. Notre expertise médicale couplée à une plateforme technologique de pointe nous permet d’offrir une prise en charge complète du patient, allant du prélèvement de « routine » aux analyses les plus spécialisées. Découvrez nos valeurs et notre équipe.
Nos engagements
Au sein du Laboratoire d’analyses médicales Ketterthill, nous considérons la responsabilité sociétale de l’entreprise comme inhérente à notre engagement à faire progresser la santé et la prise en charge des patients. En savoir plus.
Recrutement
La politique des ressources humaines du laboratoire Ketterthill s’articule autour du développement des compétences et de la gestion des talents. Nous encourageons la polyvalence et l’apprentissage continu à travers de nombreuses opportunités de formation.
Vous êtes à la recherche d’une nouvelle opportunité de carrière ?
Notre réseau associe expertise et proximité avec 300 collaborateurs présents dans nos 70 centres et lieux de prélèvement au Luxembourg.
Nous recrutons régulièrement de nouveaux talents désireux de nous accompagner dans notre développement et souhaitant relever des défis professionnels variés.
Rejoignez-nous!